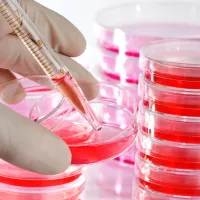
Petri Dishes 90 x 15mm Plastic B/500

Lablads Products
- All Products
-
Biochemicals and Reagents

-
Cell and Molecular Biology

-
Clinical Diagnostics

-
Consumables

-
Environmental and Water Testing

-
Glassware

-
Liquid Handling

-
Laboratory Equipment

-
Water, Mining and Industrial Chemicals

-
Plant Tissue Culture and Microbiology

-
Plasticware

-
Safety and PPE

-
Analytical Chemicals